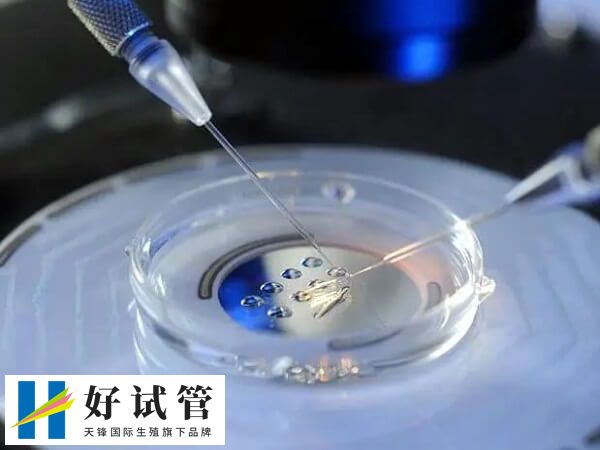
移植胚胎的质量好可提高龙凤胎生育几率

移植两个鲜胚能不能怀龙凤胎
在试管婴儿治疗中,患者移植两个鲜胚确实会增加怀双胞胎的可能性,但并不能直接实现龙凤胎,毕竟龙凤胎通常指的是同时怀有一个女孩和一个男孩。虽然做试管看提高怀孕的几率,但该项技术只能提高怀孕的成功率,却并不能控制胎儿的性别。
鲜胚移植与龙凤胎的关系
鲜胚移植是实现试管婴儿的常用方法之一。该方法将男女双方的卵子和精子在体外受精,培养成早期胚胎,并将其移植回母亲子宫内,从而期待着新生命的诞生。但移植两个鲜胚对于患者来说适应的人群不会很多,毕竟经过试管促排之后的患者卵巢会受到一定刺激,需要时间调理后移植才会有更高的成功率。

同时移植两个鲜胚出现生育龙凤胎是很有争议的。原因在于被移植胚胎的质量和它们最终着床的位置都可能对龙凤胎的出现产生影响。但要想生育出龙凤胎,就需要在试管婴儿过程中,将两个胚胎同时移植回母亲子宫内,才有可能出现龙凤胎,但临床上适应移植两个胚胎的患者在少数,所以生龙凤胎也不是想生就能生的。
移植胚胎后如何生龙凤胎
一般来说,移植两个鲜胚确实能够让双胞胎的可能性增加。但此外,胚胎的质量、着床的位置、以及母体的健康状况等因素也可能影响龙凤胎的出现。
1、胚胎的质量
不同的胚胎质量差异很大,能否成功妊娠甚至胚胎着床后是否能够发育成胎儿,和胚胎质量密切相关。如果两个移植的胚胎均为高品质的鲜活胚胎,那么龙凤胎自然更容易发生。
2、胚胎着床位置
胚胎着床稳定、健康与否,对于胚胎发育来说十分关键。如果只有一个胚胎着床并发育,而另一个胚胎无法着床,则不会有龙凤胎的出现。
3、母体健康状况
母体的健康状况同样为龙凤胎出现所必须考虑的问题。如果母亲已经年过四十或者有多次流产的史料,那么移植两颗鲜胚与成功妊娠后该生男生女都会受到极大的影响。





